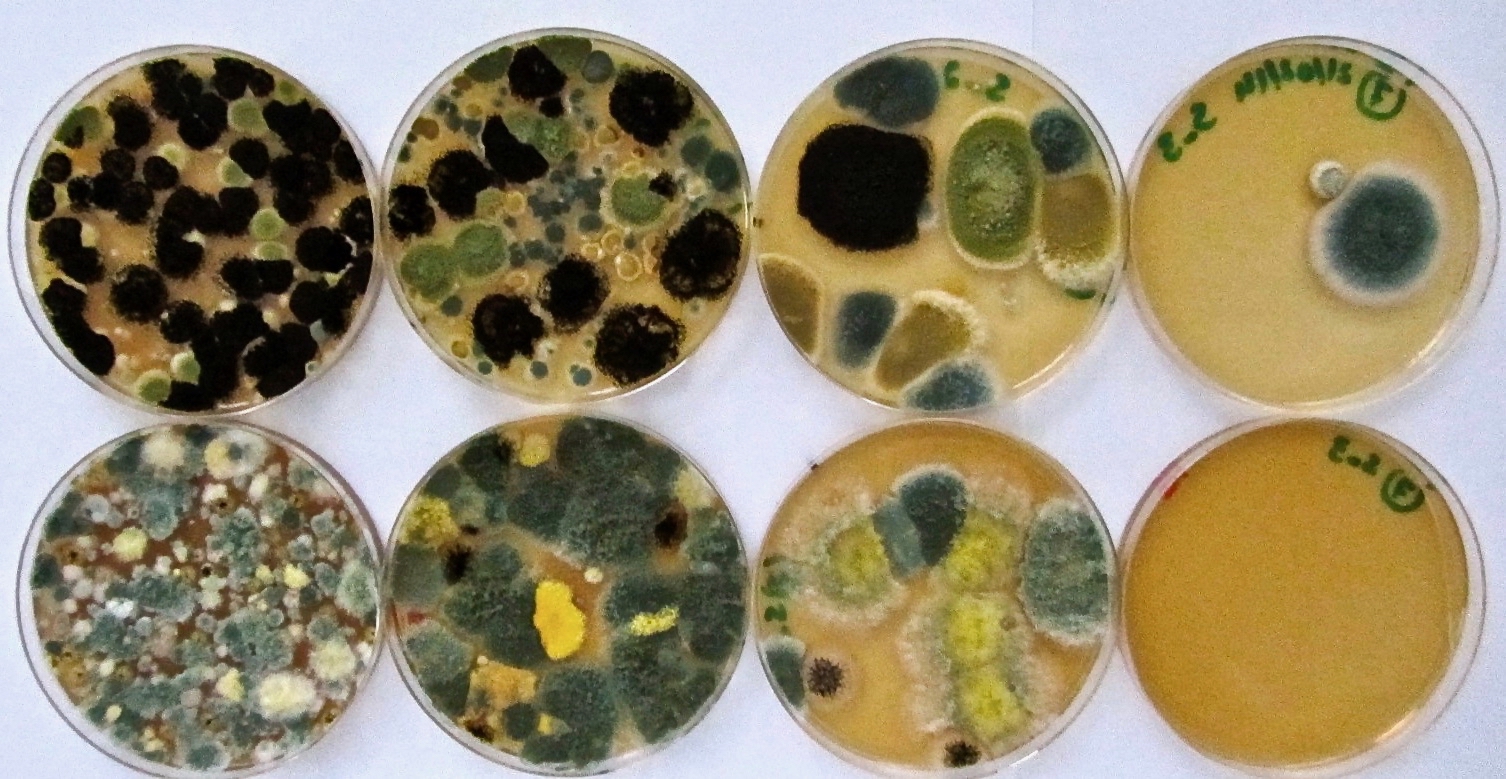
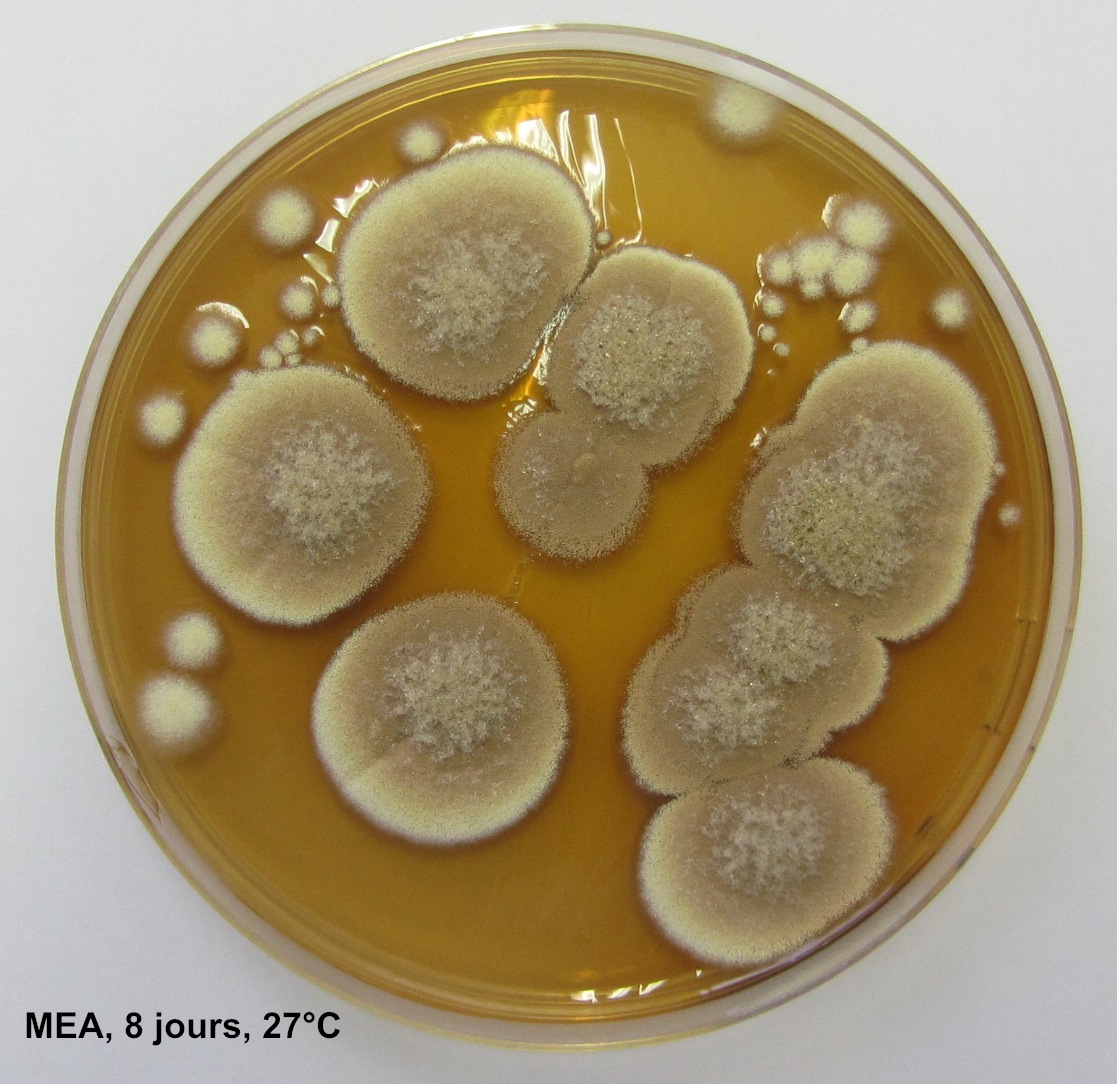
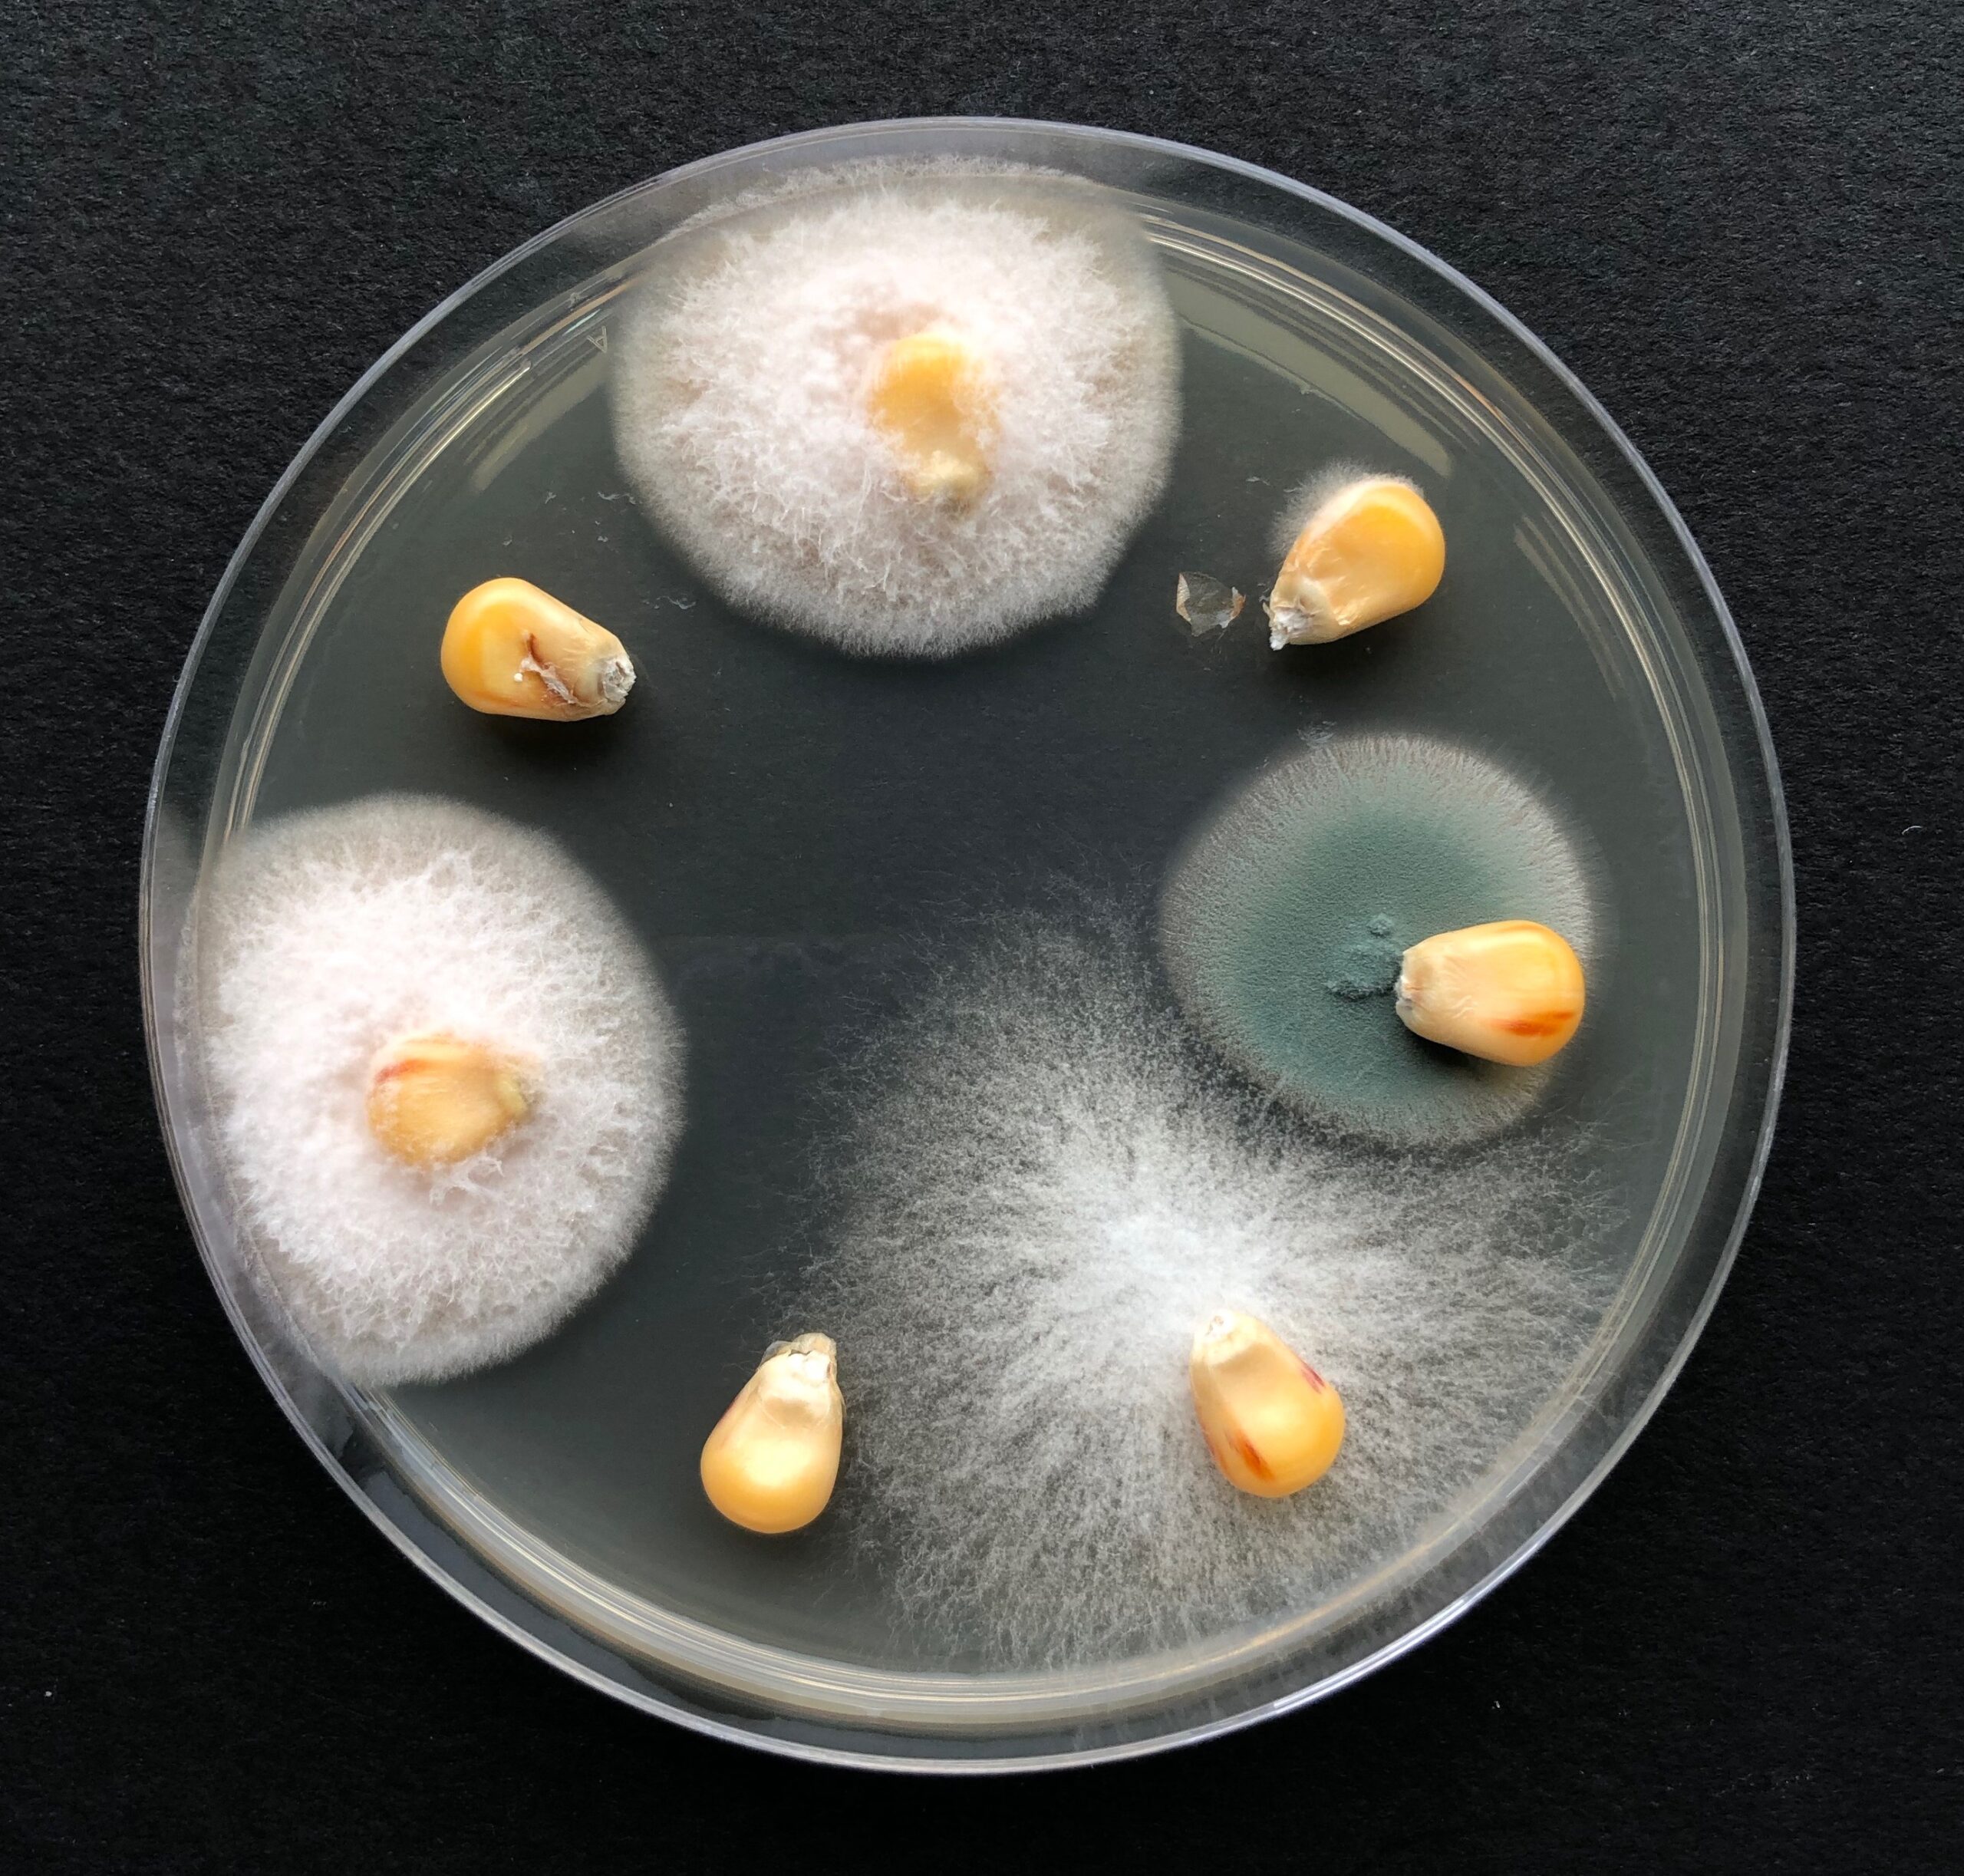

Les analyses mycologiques – matrices alimentaires
L'ANALYSE FONGIQUE CLASSIQUE
Intérêt : Dénombrement et identification de l’ensemble des moisissures vivantes présentes dans l’échantillon fourni -> compréhension de l’origine d’une altération et/ou d’un accident toxique.
Nature des échantillons : tout substrat ou aliment moisi ou suspect d’être moisi.
Recherche spécifique du Stachybotrys chartarum

Intérêt : Espèce fortement toxinogène (toxines non dosables) responsable de Stachybotryotoxicose chez les animaux et du « Syndrome du bâtiment malsain » chez l’homme…
Nature des échantillons : foin, paille, papier peint…
Recherche et comptage des spores de Pithomyces chartarum

Intérêt : Évaluation du risque d’eczéma facial pour les animaux au pâturage (toxines non dosables)
Nature des échantillons : herbe sèche
Identification morphologique d'une espèce préalablement isolée sur gélose
Nature des échantillons :Géloses (boîtes de pétri, Tubes en pente…)
évaluation flore fongique INTERNE (méthode de ulster)
Intérêt : Evaluation du pourcentage de grains infectés par des moisissures
« internes »
Nature des échantillons : grains de maïs, blé
dosage coumestrol(chromatographie couche mince)

Intérêt :Phyto-oestrogène pouvant perturber la reproduction des animaux (petits ruminants plus sensibles)
Nature des échantillons :Luzerne (foin, bouchons, granulés), trèfle